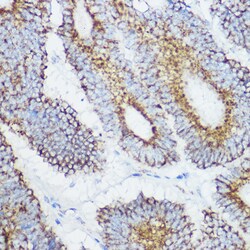
Invitrogen GluD1 Polyclonal Antibody 100 &mu;L; Unconjugated:Antibodies,
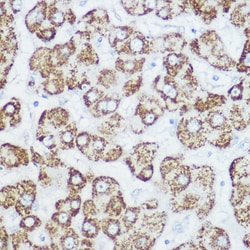
Invitrogen GluD1 Polyclonal Antibody 100 &mu;L; Unconjugated:Antibodies,
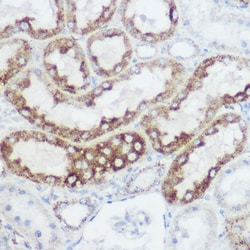
Invitrogen GluD1 Polyclonal Antibody 100 &mu;L; Unconjugated:Antibodies,

Learn More
Invitrogen™ GluD1 Polyclonal Antibody


Rabbit Polyclonal Antibody
Brand: Invitrogen™ PA5121121
Description
Positive test controls include: HeLa, HepG2, NIH/3T3, U-251MG, Mouse liver, Mouse brain, Rat liver, Rat brain, Rat kidney. The target is usually found in the following locations: Mitochondrion matrix. Immunogen sequence: SEAVADREDD PNFFKMVEGF FDRGASIVED KLVEDLRTRE SEEQKRNRVR GILRIIKPCN HVLSLSFPIR RDDGSWEVIE GYRAQHSQHR TPCKGGIRYS TDVSVDEVKA LASLMTYKCA VVDVPFGGAK AGVKINPKNY TDNELEKITR RFTMELAKKG FIGPGIDVPA PDMSTGEREM SWIADTYAS.
Glutamate dehydrogenase, GluD1, is a mitochondrial matrix enzyme that catalyzes the oxidative deamination of glutamate to alpha-ketoglutarate and ammonia. This enzyme has an important role in regulating amino acid-induced insulin secretion. It is allosterically activated by ADP and inhibited by GTP and ATP. Activating mutations in this gene are a common cause of congenital hyperinsulinism. Alternative splicing of this gene results in multiple transcript variants. The related glutamate dehydrogenase 2 gene on the human X-chromosome originated from this gene via retrotransposition and encodes a soluble form of glutamate dehydrogenase. Related pseudogenes have been identified on chromosomes 10, 18 and X.
Specifications
| GluD1 | |
| Polyclonal | |
| Unconjugated | |
| GLUD1 | |
| Ac2-281; AI118167; brain glutamate dehydrogenase; epididymis tissue sperm binding protein Li 18mP; GDH; GDH 1; GDH 2; Gdh1; GDH2; Gdh-X; Glud; GLUD1; GLUD1 protein; GLUD2; Gludeha; Gludl; GLUDP1; gluR delta-1 subunit; GluRdelta1; glutamate dehydrogenase; glutamate dehydrogenase (NAD(P)+); glutamate dehydrogenase 1; glutamate dehydrogenase 1, mitochondrial; glutamate dehydrogenase 2; glutamate dehydrogenase 2, mitochondrial; glutamate dehydrogenase pseudogene 1; glutamate ionotropic receptor delta type subunit 1; glutamate receptor delta-1 subunit; glutamate receptor ionotropic, delta-1; glutamate receptor, ionotropic, delta 1; Grid1; KIAA1220; Membrane protein 50; memory-related gene 2 protein; MP50; MRG-2; testicular secretory protein Li 14 | |
| Rabbit | |
| Affinity chromatography | |
| RUO | |
| 14661, 24399, 2746 | |
| -20°C, Avoid Freeze/Thaw Cycles | |
| Liquid |
| ELISA, Immunohistochemistry (Paraffin), Immunoprecipitation, Western Blot, Immunocytochemistry | |
| 1.02 mg/mL | |
| PBS with 50% glycerol and 0.09% sodium azide; pH 7.3 | |
| P00367, P10860, P26443 | |
| GLUD1 | |
| Recombinant fusion protein containing a sequence corresponding to amino acids 54-242 of human GLUD1 (NP_005262.1). | |
| 100 μL | |
| Primary | |
| Human, Mouse, Rat | |
| Antibody | |
| IgG |
Your input is important to us. Please complete this form to provide feedback related to the content on this product.